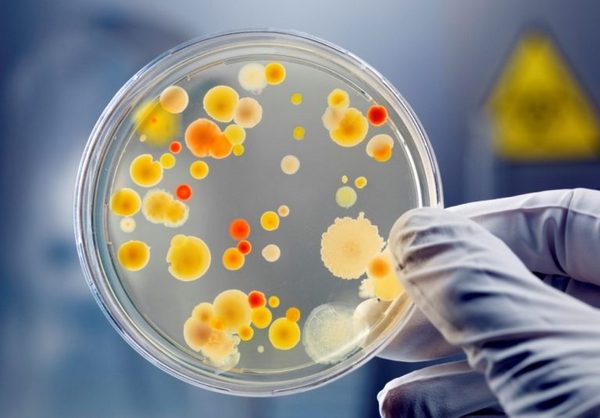

Болячки продовжують атакувати Борзнянський інтернат
12 березня на стаціонарне лікування до інфекційного відділення Борзнянської райлікарні госпіталізовано трьох працівників Борзнянської спеціалізованої школи-інтернату. Тепер у лікарні перебуває вже 19 осіб, з яких 16 — учні.
У 11 дітей підтверджено діагноз «сальмонельоз», у трьох учнів — гостра кишкова інфекція невизначеної етіології, у двох школярів — гостра кишкова інфекція цитробактер. Стан хворих — середньої тяжкості (13 осіб) та легкої тяжкості (6 осіб, з них три дитини). Навчальний процес у школі-інтернаті призупинено.
— Що таке цитробактер, які симптоми?
— Такі ж самі, як і при інших кишкових інфекціях. Діагноз встановлено після спеціальних лабораторних досліджень, — пояснює 55-річна Алла Яковенко, завідуюча інфекційним відділенням Борзнянської райлікарні. — Нині пацієнти на обстеженні і лікуванні. Лікуємо за рахунок надання невідкладної допомоги. Проводимо детоксикацію, антибактеріологічну терапію за кошти як
інтернату, так і самих пацієнтів. Усе залежить від того, які препарати потрібні.
Нагадаю, у лікарню діти почали поступати з 23 лютого. З проносом, блювотою, нудотою, температурою, головним болем, слабкістю. Усі, хто захворів, їли в тому числі і в школі-інтернаті. Найбільше учнів вразив сальмонельоз. Він живе у м’ясі, молоці, яйцях. Не боїться заморозки і температури під 80. Але гине при тривалому кип’ятінні. Яйця, наприклад, треба варити 10 хвилин. Хвороба заразна.
— Джерело інфікування ще досі не встановлене. Із дорослих, котрі потрапили до лікарні, двоє працівників кухні і один педагог, — сказав Іван Вовк, виконувач обов’язків завідувача Борзнянського міжрайонного відділу Чернігівського обласного лабораторного центру.
Тим часом поліція і прокуратура продовжують встановлювати причину спалаху кишкової інфекції. Провадження відкрито за фактом неналежного виконання професійних обов’язків.
Валентина Остерська, тижневик «Вісник Ч» №11 (1662), 15 березня 2018 року
Хочете отримувати головне в месенджер? Підписуйтеся на наш
Telegram.




